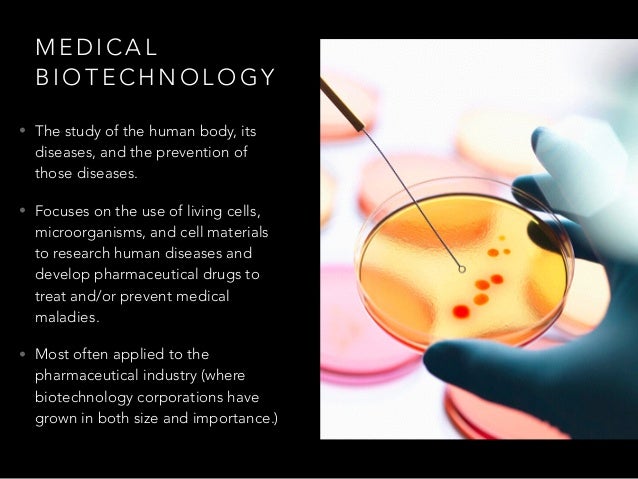

Biotech Branche
Right at the border between Switzerland, Germany and France, Basel has become a hotspot for biotech and pharma Actelion, one of the largest companies in the history of European biotech, was born here years ago, culminating its success story in a massive $30Bn acquisition last year In Basel we can find topnotch companies such as Actelion’s spinoff Idorsia.
Biotech branche. The Research Technologies Branch (RTB) allows investigators in the Division of Intramural Research access to stateoftheart research technologies During the past 30 years, the advent of the biotechnology industry and the development of new scientific disciplines have resulted in an explosion of new technologies In addition, advances in optics, lasers, and computer technology have. Biotechnology is an interdisciplinary branch of science which is popular among youngsters as it is providing ample opportunities for those who want to explore the new and modern frontiers of science It does not refer to a specific industry or job The applications of Biotechnology is vast as it caters to various industrial sectors like food. The aim of biotechnology is to improve and advance the human’s living conditions With the passage of time, this technology is growing on and resulting in numbers of helpful applications Biotechnology has various branches further, like Green biotechnology, Blue biotechnology, Red biotechnology, White biotechnology, Bioinformatics etc.
ABOUT BIOTECH BIOTECH pvt ltd co is one of the fastest growing companies in terms of capital investment, human power development, good will and other sphere of the activities in the field of Veterinary and human Pharmaceuticals and medical equipment importing in Ethiopia The company established in 1991 GC as per commercial law of Ethiopia. Biotechnology is branch of science in which living things are used to make new products • It is the use of living organisms or processes to make products useful for mankind 5. The Research Technologies Branch (RTB) allows investigators in the Division of Intramural Research access to stateoftheart research technologies During the past 30 years, the advent of the biotechnology industry and the development of new scientific disciplines have resulted in an explosion of new technologies In addition, advances in optics, lasers, and computer technology have.
Established in 1997, Biotechnology International Co LLC set up a modern factory in Jebel Ali Free Zone for the manufacture of Superior quality personal care products, Household cleaning solutions, Detergents & other chemical solutions that include automotive maintenance products. Because it resonates with and makes sense to us CAPA means Corrective And Preventive Action, while BioTech stands for life and technology Our aim is for CAPA BioTech to become the preferred, trusted and reliable supplier for healthcare institutions, governments, airports and companies worldwide and deliver the safest, best possible services and products to their patients, clients and customers. International SERVICE Biotech Dental 305 Allées de Craponne Salon de Provence – France Contact Nabila Abed Tel 33 (0)4 90 44 60 60 Fax 33 (0)4 90 44 60 61.
Biotechnology is that branch of science which gained popularity in the 1970s This is a Science which through different biological processes exploits organisms, cells, or/and cellular components to develop new technology Biotechnology is proven to be very useful in the field of agriculture, medicine, industry, and environmental studies. Plant biotechnology is a combination of tissue culture and genetic engineering It deals with development of transgenic plants with resistance to biotic and abiotic stresses;. Animal Biotechnology is a branch of biotechnology in which molecular biology techniques are used to genetically engineer animals in order to improve their suitability for pharmaceuticals ,agricultural or industrial applications 5.
Development of haploids, embryo rescue, clonal multiplication, cryopreservation, etc The main features of plant biotechnology are briefly presented below. Bharat Biotech is a pioneering biotechnology company known for its worldclass R&D and manufacturing capabilities Our mission is to deliver affordable, safe and highquality vaccines and biotherapeutics that help people prevail over diseases. Biotech Partners finds the talent that finds the cure From helping you find the perfect life sciences candidate or matching applicants up with their dream role, you’ll find Biotech Partners committed to your success That’s why we have a 5year quality guarantee.
0 {{featured_button_text}} 1 of 2 Soybeans in a field near Mansfield, Ill Photo taken. Gene therapy is another branch of biotech that has been around for decades, but it was only recently that technology advanced to a point where the technique was both consistent and costeffective. Creve Coeur biotech company, Benson Hill, branches into the seed business Bryce Gray Dec 4, 19 Dec 4, 19;.
List of Top Pharma/Biotech Companies in France. A series of derived terms have been coined to identify several branches of biotechnology, for example Bioinformatics (also called "gold biotechnology") is an interdisciplinary field that addresses biological problems using computational techniques, and makes the rapid organization as well as analysis of biological data possible. BioTechne's Mission is to build Epic Tools for Epic Science We have a creative, caring team of colleagues throughout the world who bring unique perspectives and talents in support of that Mission and who embody our four key Values Empowerment, Passion, Innovation and Collaboration.
The aim of biotechnology is to improve and advance the human’s living conditions With the passage of time, this technology is growing on and resulting in numbers of helpful applications Biotechnology has various branches further, like Green biotechnology, Blue biotechnology, Red biotechnology, White biotechnology, Bioinformatics etc. Branch of biotechnology that alters the genes in biological organisms to achieve a medicinal or agricultural purpose Bioremediation using microorganisms to change harmful chemicals into harmless ones Agriculture science related to farming and raising crops for consumption Penicillin. The Research Technologies Branch (RTB) allows investigators in the Division of Intramural Research access to stateoftheart research technologies During the past 30 years, the advent of the biotechnology industry and the development of new scientific disciplines have resulted in an explosion of new technologies In addition, advances in optics, lasers, and computer technology have.
HONG KONG (Reuters) Chinese biotech company Abbisko Therapeutics Co has raised $123 million from more than a dozen investors, including Carlyle Group and Warburg Pincus, in its latest funding. Biotechnology is also used to recycle, treat waste, cleanup sites contaminated by industrial activities (bioremediation), and also to produce biological weapons A series of derived terms have been coined to identify several branches of biotechnology, for example 1 Bioinformatics. Biotechnology for sure is an expansive territory of biology which includes living systems and life forms which are interdependent on each other either to create or make items, or any mechanical application that utilizes natural frameworks, living creatures, or subsidiaries thereof, to make or adjust items or procedures for explicit use.
What if we could solve both carbon reduction & sustainable food production in one step Deep Branch is a carbon recycling biotechnology company We use microbes to convert carbon dioxide from industrial emissions into highvalue products We’re a fastgrowing and agile startup with commercial activities both in the UK and the Netherlands. BCFB is a collection of six laboratories which encompass the key biotechnology areas including Genomic Sequencing, Proteomics/Protein Chemistry, Scientific Computing/Bioinformatics, DNA synthesis, Peptide Synthesis, and Molecular Assays Development. • GloFish, the first biotech pet, hits the North American market • Worldwide biotech crop acreage rises 15 percent to hit 1672 million acres in 18 countries Brazil and the Philippines biotechnological crops grow for the first time in 03 Indonesia allows consumption of imported biotech food and China and Uganda accept biotech crops.
We are a biotech company specialized in the research, development, and commercialization of innovative and technological food additives hydrocolloids Agar Agar, Carrageenan, and TailorMade Stabilizer Solutions With the extended knowhow and experience in the research, application, and use of Hydrocolloids, we could provide onestopshop customized solutions perfectly matched to the needs of. Biotechnology, the use of biology to solve problems and make useful products The most prominent area of biotechnology is the production of therapeutic proteins and other drugs through genetic engineering Learn more about the development and applications of biotechnology in this article. Our Address Table of Contents Biotecnika info Labs Pvt Ltd Head OfficeBangalore Academic Branch OfficeDelhi & NCR Branch Office Biotecnika info Labs Pvt Ltd Head Office #1848/c, Ground Floor, th Main, 18th Cross, Sector1, HSR Layout, Bangalore – PhNo TollFree Bangalore Academic Branch Office #427, 1st Floor, 27th Main, Sector1 HSR Layout,.
Biotech Bargains 377 followers biotechct ( 6597 biotechct's feedback score is 6597 ) 994% biotechct has 994% Positive Feedback Welcome to the Connecticut branch of Biotech Bargains, LLC. The largest biotech company in the world is Johnson & Johnson, founded in 15 as a provider of readytouse surgical dressings Today, this company is a multinational pharmaceutical, medical devices, and first aid supplies manufacturer Some of the most well known Johnson & Johnson brands include Tylenol, Neutrogena, BandAid, Acuvue contact. In biotechnology, career paths can have many branches Careers often begin with technical education at two or fouryear colleges Community colleges prepare students for working in industry by providing handson education through associates and bachelors degree programs These colleges also offer certificates that focus on technical skills As individuals gain experience,.
Learn about Top Pharma/Biotech Companies in France Search the France Pharma/Biotech Database and identify potential partners in the France Biotech, Pharma and Medtech industry Note If you would like to list your Biotech company on our website, please feel free to contact us or visit our page List your Pharma / Biotech Company!. The science of biotechnology can be classified into following branches Red Biotechnology It is simply medical biotechnology This one is applied to medical processes Some of them are listed below Use of organisms for the production of drugs or antibiotics. Gene therapy is another branch of biotech that has been around for decades, but it was only recently that technology advanced to a point where the technique was both consistent and costeffective.
Some of the areas in which biotechnology is making marked contributions are Human Health, Animal Health, Agriculture, Medicine, Forestry Fisheries, Mining, Environment, Horticulture, Floriculture, Dairy, Food processing, Animal Husbandry, Renewable energy, Crime detection, parental dispute, Aquaculture etc Biotechnology basically aims at improving the quality of human life and at protecting him from dangerous diseases. Die Hoffnung auf Schutz vor dem Coronavirus rückt Aktien von Pharma und BiotechUnternehmen in den Blick Gerade in dieser schwer durchschaubaren Branche aber sollten Anleger mehrere Ratschläge. Icici Bank Ncr Biotech Branch is located in Faridabad district of Haryana state IFSC Code of Icici Bank, Ncr Biotech Branch is ICIC ICIC IFSC code could be used for fund transfer through NEFT, IMPS or RTGS to Icici Bank Ncr Biotech Branch, Faridabad.
Biotechnology is a broad area of biology, involving the use of living systems and organisms to develop or make productsDepending on the tools and applications, it often overlaps with related scientific fields In the late th and early 21st centuries, biotechnology has expanded to include new and diverse sciences, such as genomics, recombinant gene techniques, applied immunology, and. Biotech firm branches into Australia and New Zealand Print Details Written by Chris Remington Published 06 November GREENSBORO – US biotechnology specialist Novālent has announced that it will launch its antibacterial solution in both Australia and New Zealand following recent success in its homeland Log in or subscribe to see this. The biotechnology or ‘biotech’ sector is one of the hardest sectors to invest in Bitech investing is for the robust investor seeking high risk/reward on a roller coaster It’s not for the risk averse.
Branches Of Biotechnology Biotechnology has more than a few different branches which are referred to by dissimilar terms mainly noticeable with dissimilar colors to clarify the biotechnological field that it is used in The majority extensively used ones will be introduced here. Animal Biotechnology is a branch of biotechnology in which molecular biology techniques are used to genetically engineer animals in order to improve their suitability for pharmaceuticals ,agricultural or industrial applications 5. Biotechnology is a worldwide business The BiotechCareers biotechnology, pharma, and medical device company directory has 8,303 potential employers engaged in 525 business activities that are located in 11,619 sites throughout the world Use the maps below to view biotech employer locations in specific states, the United States or the world.
Biotechnology has more than a few different branches, which are referred to by dissimilar terms mainly noticeable with dissimilar colors to clarify the biotechnological field that it is used in The majority of extensively used ones will be introduced here. Over 3,500 biotech companies generate employment, contribute to the country’s economy and facilitate a sustainable environment By 25, we aim to be worth a $150 billion industry While the increased budget is a welcome step, the target investment in R&D is a reflection of the government’s commitment to keeping the industry flush with. In biotechnology, career paths can have many branches Careers often begin with technical education at two or fouryear colleges Community colleges prepare students for working in industry by providing handson education through associates and bachelors degree programs These colleges also offer certificates that focus on technical skills As individuals gain experience,.
Newgen Biotech® USA Inc and its sister company Newgen Biotech®(Ningbo) Co Ltd are a new generation manufacturer & distributor for the cosmetic, personal care and dietary supplement industries Due to the broad reach of our product offering, we also have a presence in other industries such as food & beverage etc Make sure to visit our. Biotechnology is a branch of molecular biology having applications of technological revolution related to biology and life sciences Studies have shown that bionanotechnology and nanobiotechnology has been interchanged, although these two terms are distinguished and a distinction has been drawn between the two. The core branches in the IITs that are highly famous amongst students are Computer Science and Electrical The other branches that follow are Mechanical, Aerospace Engineering, Engineering Design, Civil Engineering, Chemical Engineering, Metallurgy, Biotechnology and Naval Architecture.
International SERVICE Biotech Dental 305 Allées de Craponne Salon de Provence – France Contact Nabila Abed Tel 33 (0)4 90 44 60 60 Fax 33 (0)4 90 44 60 61. Gene therapy is another branch of biotech that has been around for decades, but it was only recently that technology advanced to a point where the technique was both consistent and costeffective. Bharat Biotech is a pioneering biotechnology company known for its worldclass R&D and manufacturing capabilities Our mission is to deliver affordable, safe and highquality vaccines and biotherapeutics that help people prevail over diseases.
VEGION BIOTECH LIMITED COMPANY BRANCH can supply best quality Food & Beverages and many more Vietnam Fresh Young Coconut,Dried Coconut,Coco Fiber,Rice goods, as they are a identified Manufacturer The manufactory of VEGION BIOTECH LIMITED COMPANY BRANCH is sited in No 99 Nguyen Thi Minh Khai Street, Ben Thanh Ward, District 1, HCM City, Viet. Synonyms for biotech in Free Thesaurus Antonyms for biotech 1 synonym for biotech biotechnology What are synonyms for biotech?. Ncr Biotech Branch Icici Bank Ltd IFSC, address, branch phone number, manager contact number, email address Icici Bank Ltd Ncr Biotech is located at Haryana state, Faridabad district, Faridabad city and the bank branch's address is Ncr Biotechscience Cluster, 3rd Milestone, Faridabad Gurgaon Expressway Faridabad.
Biotechnology is the branch of biology that harnesses cellular and biomolecular processes to develop technologies and products that help enrich our lives and the wellbeing of our planet In this article, we will explore top 10 biotechnology news in 17. The Biotechnology Core Facility Branch is committed to providing high quality synthetic biopolymer reagents and advanced analytical methodology to the CDC scientific community BCFB provides access to cuttingedge instrumentation and platforms as well as specialized expertise in the areas of structural analysis and synthesis of biopolymers. The biotechnology or ‘biotech’ sector is one of the hardest sectors to invest in Bitech investing is for the robust investor seeking high risk/reward on a roller coaster It’s not for the risk averse.
Branches/Classification/Areas of Biotechnology Following are the Important Classification of Biotechnology BioInformatics Bioinformatics is an interdisciplinary field that tends to biological issues utilizing computational systems, and makes the fast association and additionally examination of organic information conceivable.
Zew Lobt Staatliche Forderung In Biotech Branche Chemanager
The Three Branches Of Biotechnology

Media Tweets By Stimos Gmbh Med Stimos Twitter
Biotech Branche のギャラリー
Q Tbn And9gcq0stolqovcq9y2p3narzt4osdlkll8dk7kddvgd Rvhty I Dl Usqp Cau

Pure Muscle Supplements Biotech Usa

Biotech Round Table Mc Services Corporate Website

Top Branches Of Biotechnology And Job Scope In Trybiotech

Rekord Bei Finanzierungen Deutsche Biotech Branche Wachst Pz Pharmazeutische Zeitung

Wachsende Biotech Branche In Bayern

Reference Microsart Manifold Pour Unites Biosart 100 Without Funnels 1 Branche Kisker Biotech Laboratory Equipment

The Three Branches Of Biotechnology

Biotech Branche Hofft Auf Wachstumsschub Durch Corona Erfolge
1

Pdf Modern Approaches To Classification Of Biotechnology As A Part Of Nbic Technologies For Bioeconomy

Pdf Modern Approaches To Classification Of Biotechnology As A Part Of Nbic Technologies For Bioeconomy

Corona Wie Anleger In Die Biotech Branche Investieren Konnen

Aufbruchstimmung In Der Biotech Branche

The Three Branches Of Biotechnology

Deutsche Biotech Branche Wachst
Wuxi Biologics
Pharma Leinfelden Echterdingen Biotech Branche Hofft Auf Durchbruch Bei Corona Forschungen Wirtschaft Sz De

Biotech Branche Wachst Und Spurt Gegenwind Mnews Medianet At
Q Tbn And9gcszrime2t98nku8zflp4pzfzmaz4hchdjtfbi7xqaasmou0zrxn Usqp Cau

The Evolution Of The Biotechnology Industry In Germany Trends In Biotechnology

Orange On The Branche Of A Tomatoes New Genetic Engineering Stock Photo Picture And Royalty Free Image Image
Q Tbn And9gcqltvjznrc3vpkv5n0htg86gb1vemrjmjnaj9dp5spa0uuyvknm Usqp Cau

Lauda Biotechnology

Top 6 Issues Facing The Biotechnology Industry Drugpatentwatch Make Better Decisions

Spezialisten Gesucht Fachkraftemangel In Der Pharma Und Biotech Branche

General Outlook On 5 Major Branches Of Biotechnology

History Bioengineering

Top 6 Issues Facing The Biotechnology Industry Drugpatentwatch Make Better Decisions

Biotechnologie Branche In Deutschland Ist In 19 Teils Zweistellig Gewachsen
Deutsche Biotech Branche Auf Stabilem Wachstumskurs

Xconomy Arch S Bob Nelsen On Big Biotech And Why Pharma Should Be Very Afraid

Biotechnology Industry Is Attracting The Interest Of Pharmaceutical Companies Credit Suisse Switzerland
:max_bytes(150000):strip_icc()/biotech.ap09090305308-5bfc3804c9e77c00587a692c.jpg)
Biotech Vs Pharmaceuticals What S The Difference

Fabrizio Sibilla Fabriziosibilla Twitter

Hennigsdorf Die Biotech Branche Vernetzt Sich

Sustainability Free Full Text Potential Pathways To The German Bioeconomy A Media Discourse Analysis Of Public Perceptions Html

The Three Branches Of Biotechnology

Wette Auf Die Zukunft Biotech Branche Mit Nur Wenigen Leuchtturmen

The Three Branches Of Biotechnology

Top Branches Of Biotechnology And Job Scope In Trybiotech

Seo Biotech Branche Biotechnologie Youtube

Pdf Modern Approaches To Classification Of Biotechnology As A Part Of Nbic Technologies For Bioeconomy

Pdf The Rise Of Venture Capital And Biotechnology In The Us And Europe

Schweiz Umsatz Der Grossten Chemie Pharma Und Biotech Branche Nach Regionen 18 Statista

Laborjournal Nicht Erst Seit Der Coronapandemie Spielt Osterreichs Biotech Branche Gross Auf Grund Genug Sich Nun In Dem Eigenen Lobbyverband Biotech Austria Zusammenzutun Sciencekathi Stellt Ihn Uns Vor T Co Pzeykxpwqa
The Record Breaking Biotech Funding Tsunami Of 1h

Firmenumfrage 14 Biotech Branche Mit Gemischter Bilanz Biookonomie De

Deutsche Biotech Branche Hofft Auf Den Bill Gates Effekt Welt
Genetic Engineering Biotechnology Concept Stock Image Image Of Healthy Eating

Sap Grunder Hopp Die Biotech Branche Braucht Durchschlagende Erfolge Wsj

Die Lang Unterschatzte Biotechnologie Branche 10x10 Ch Next Generation Invest Etf Indexfonds Krypto Themen

Branches Of Biotechnology Biotech Genetic Information

Biotech Branche Ist Gefahrlich Abhangig Von Us Investoren

Corona Biotech Branche Hofft Auf Durchbruch Bei Covid 19 Forschungen

Laborjournal Nicht Erst Seit Der Coronapandemie Spielt Osterreichs Biotech Branche Gross Auf Grund Genug Sich Nun In Dem Eigenen Lobbyverband Biotech Austria Zusammenzutun Sciencekathi Stellt Ihn Uns Vor T Co Pzeykxpwqa

Pdf The Rise Of Venture Capital And Biotechnology In The Us And Europe
The Record Breaking Biotech Funding Tsunami Of 1h
Biotechnology Wikipedia

Pdf Modern Approaches To Classification Of Biotechnology As A Part Of Nbic Technologies For Bioeconomy

Free Sample Taiwan Skincare Obm Odm Private Label Best Whitening Cream Sunscreen Cream Taiwantrade Com

Wie Wirkt Sich Corona Auf Die Bayerische Biotech Branche Aus Interview Biom Youtube

Biotech Die Branche Wachst Und Hat Ruckenwind Wirtschaft Regional Rnz

Challenges And Implications For Technology Transfer In Biotechnology Pdf Free Download
Ubs Lux E F Biotech Usd P A Usd 859 15 Usd Teletrader Com

Top Branches Of Biotechnology And Job Scope In Trybiotech

Biotech Branche Wieder Auf Wachstumskurs Chemanager

C Lecta Gmbh Clecta Twitter

Schweizer Biotech Branche Wachst Unternehmen Gesundheit Finanz Und Wirtschaft

Risikoscheue Investoren Biotech Boomt Nur Nicht In Deutschland

Erp For The Biotechnology Industry Yaveon Ag

Aktienmarkt Biotech Branche Feiert Glorreiches Borsencomeback Welt

Vienna Biocenter Wikipedia

Schweizer Biotech Branche Bluht Punkt4

Branches Of Biotechnology Biotech Genetic Information

Pdf Modern Approaches To Classification Of Biotechnology As A Part Of Nbic Technologies For Bioeconomy
:max_bytes(150000):strip_icc()/GettyImages-1156476547-fab45091852d43f4a51430a6184b4e61.jpg)
Biotech Vs Pharmaceuticals What S The Difference

Pharma Home

Pdf What Is Business Development The Case Of Biotechnology

Orange On The Branche Of A Tomatoes Genetic Engineering Biotechnology Concept Image Isolated On A White Background
Biotechnology Wikipedia

Orange On Branche Tomatoes New Genetic Stock Photo Edit Now

Biotech Aussichten Dank Neuausrichtung Ordentlich

Biotech Branche Wachst Kraftig Transkript

Deutsche Biotech Branche Weiter Im Aufwind Transkript

Pdf Fish Peptones As Nitrogenous Substrates For The Fermentation Industry

Impfstoffentwicklersorgenfurfinanzierungsrekordin Biotech Branche Derspiegel Wirtschaft Youtube

Biotechnology Wikipedia

General Outlook On 5 Major Branches Of Biotechnology

Corona Krise Biotech Branche In Sachsen Gewinnt An Bedeutung

Top Branches Of Biotechnology And Job Scope In Trybiotech

Inkl Andhra Bank Files Insolvency Proceedings Against Sterling Biotech Livemint

Gempex The Gmp Expert Biotechnology

General Outlook On 5 Major Branches Of Biotechnology

The Three Branches Of Biotechnology

Sartorius Establishes Scientific Advisory Board

General Outlook On 5 Major Branches Of Biotechnology

Finanzierung Biotech Branche Forscht Und Bettelt Wirtschaft esspiegel

Annual Report The Central Resource For The Swiss Biotech Industry Pdf Free Download

Biotech Branche 10 Vergleich Europa Usa Statista

Out Licensing Pharma Iq



